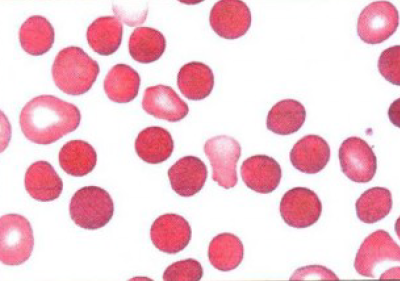

笨笨们的提问Web用户
Q
ningningzhang
2026年03月06日 09:59
问题编号: 29739
胸腔积液LD活性最高的是
A.恶性积液
B.化脓性积液
C.结核性积液
D.渗出液
E.漏出液
A.恶性积液
B.化脓性积液
C.结核性积液
D.渗出液
E.漏出液
问1:老师您好,我在书中看到恶性LDH>500,结核性LDH>200,所以应该选A呀
Q
张严
2026年03月06日 09:15
问题编号: 11006
尿糖检测的最佳标本是
A.晨尿
B.3小时尿
C.随机尿
D.导尿标本
E.24小时尿
A.晨尿
B.3小时尿
C.随机尿
D.导尿标本
E.24小时尿
问1:最佳标本是a吗
Q
WyuEe
2026年03月05日 22:33
问题编号: 31741
反映血管壁和血小板在止血和血栓形成中的作用的实验是
A.毛细血管脆性试验
B.出血时间
C.血小板计数
D.血块收缩时间
E.凝血时间测定
A.毛细血管脆性试验
B.出血时间
C.血小板计数
D.血块收缩时间
E.凝血时间测定
问1:为什么不选A
Q
可爱
2026年03月05日 21:58
问题编号: 30581
AML-M3原始细胞扫描电镜下特征为
A.表面出现皱膜,也可有少许嵴样突起
B.表面有高而窄的嵴样突起
C.表面光滑、相对光滑或出现短微绒毛
D.表面有一些结节状突起,一般无绒毛和皱折突起
E.表面出现长而多的微绒毛
A.表面出现皱膜,也可有少许嵴样突起
B.表面有高而窄的嵴样突起
C.表面光滑、相对光滑或出现短微绒毛
D.表面有一些结节状突起,一般无绒毛和皱折突起
E.表面出现长而多的微绒毛
问1:A也是嵴样突起呀,为啥不选!
Q
15021821575
2026年03月05日 00:34
问题编号: 31196
浆细胞表达的抗原是
A.CD10
B.CD19
C.CyCD22
D.Sml9
E.CyIg
A.CD10
B.CD19
C.CyCD22
D.Sml9
E.CyIg
问1:可以标记没有做的题目吗?显示10道没有做,要从头开始找?
Q
魏康
2026年03月05日 00:03
问题编号: 40283
电泳法分离血浆脂蛋白时,从正极~负极依次顺序的排列为
A.CM→VLDL→LDL→HDL
B.VLDL→LDL→HDL→CM
C.LDL→HDL→VLDL→CM
D.HDL→VLDL→LDL→CM
E.HDL→LDL→VLDL→CM
A.CM→VLDL→LDL→HDL
B.VLDL→LDL→HDL→CM
C.LDL→HDL→VLDL→CM
D.HDL→VLDL→LDL→CM
E.HDL→LDL→VLDL→CM
问1:为啥不选E呢
Q
15021821575
2026年03月04日 23:41
问题编号: 39009
患者男,55岁,低热,乏力月余,抗生素和抗病毒治疗无效,查体:脾大至脐,质硬,胸骨压痛不明显,外周血象:HB100g/L,WBC55X10^9/L,分类示早幼粒细胞2%,中性中幼粒13%,晚幼粒20%,杆状16%,分叶核25%,嗜碱性粒细胞13%,淋巴细胞10%,嗜酸性粒细胞1%,血小板780X10^9/L,骨髓有核细胞增生极度活跃,以中性中幼粒,晚幼粒和杆状核粒细胞居多,原粒细胞5%,骨髓活检可见轻度纤维化,NAP积分为0,该患者最可能的诊断是
A.急性粒细胞白血病
B.慢粒(慢性期)
C.类白血病反应
D.原发性骨髓纤维化
E.原发性血小板增多症
A.急性粒细胞白血病
B.慢粒(慢性期)
C.类白血病反应
D.原发性骨髓纤维化
E.原发性血小板增多症
问1:慢粒啥意思?
Q
黄伟芬
2026年03月04日 21:10
问题编号: 39408
最常见TSH升高的甲状腺疾病
A.医源性甲亢
B.Graves病
C.垂体瘤
D.慢性淋巴细胞甲状腺炎
E.亚急性甲状腺炎
A.医源性甲亢
B.Graves病
C.垂体瘤
D.慢性淋巴细胞甲状腺炎
E.亚急性甲状腺炎
问1:老师,帮忙讲解一下这道题 ,不太理解
Q
张严
2026年03月04日 20:51
问题编号: 10956
患者,女性,18岁。3周前因急性化脓性扁桃腺炎发热,治疗后好转,近日来出现眼睑水肿、血压增高、少尿、呼吸困难、不能平卧而就诊。
若ASO检查阳性,最可能的诊断是
A.急性肾小球肾炎合并左心衰竭
B.急性上呼吸道感染
C.急性心肌炎合并左心衰竭
D.急进性高血压
E.急性肾小球肾炎
若ASO检查阳性,最可能的诊断是
A.急性肾小球肾炎合并左心衰竭
B.急性上呼吸道感染
C.急性心肌炎合并左心衰竭
D.急进性高血压
E.急性肾小球肾炎
问1:左心衰竭怎么判断的
Q
张严
2026年03月04日 20:16
问题编号: 12113
前列腺液标本采集加盖玻片的目的和原因不包括
A.防止标本污染
B.防止标本干涸
C.有利于镜检
D.因为标本量少
E.节省标本
A.防止标本污染
B.防止标本干涸
C.有利于镜检
D.因为标本量少
E.节省标本
问1:这题选项d选项好像是便于染色,别的版本上做到选d
Q
张严
2026年03月04日 20:00
问题编号: 12105

如图所示,尿液沉渣中的结晶是
A.三联磷酸盐结晶
B.胆固醇结晶
C.马尿酸结晶
D.胱氨酸结晶
E.尿酸结晶
问1:没有图
Q
张严
2026年03月04日 18:46
问题编号: 12061

如图所示,该虫卵是
A.华支睾吸虫
B.钩虫卵
C.鞭虫卵
D.蛔虫卵
E.血吸虫卵
问1:没有图
Q
张严
2026年03月04日 18:45
问题编号: 12060

如图所示,图片的管型是
A.颗粒管型
B.红细胞管型
C.蜡样管型
D.肾上皮细胞管型
E.白细胞管型
问1:没有图
Q
张严
2026年03月04日 16:39
问题编号: 10110
患者女,30岁,体检尿常规检验,发现尿糖(+),经复查发现,空腹血糖7.8mmol/L,尿糖仍(+),患者可能的病因是
A.应激性糖尿
B.糖尿病
C.家族性尿糖
D.甲状腺功能亢进
E.肾性糖尿
A.应激性糖尿
B.糖尿病
C.家族性尿糖
D.甲状腺功能亢进
E.肾性糖尿
问1:有答案是选c的
Q
张严
2026年03月04日 09:17
问题编号: 11122
患者男,30岁。因反复不明原因的腹痛就诊。检查:肝脾肿大,多发性黄色瘤。血压120/70mmHg,外周脉搏均能扪及。实验室检查:TC7.0mmol/L,TG13.2mmol/L,HDL-C1.34mmol/L,LDL-C:3.2mmol/L。血浆静置试验的结果是
A.上下清澈中间混浊
B.透明
C.上层混浊下层清澈
D.上层清澈下层混浊
E.混浊不分层
A.上下清澈中间混浊
B.透明
C.上层混浊下层清澈
D.上层清澈下层混浊
E.混浊不分层
问1:这题TC TG都高选浑浊不分层吧
Q
123456a
2026年03月04日 07:09
问题编号: 41870
观察病毒的形态和结构,适合选用的显微镜
A.普通光学显微镜
B.暗视野显微镜
C.倒置显微镜
D.荧光显微镜
E.电子显微镜
A.普通光学显微镜
B.暗视野显微镜
C.倒置显微镜
D.荧光显微镜
E.电子显微镜
问1:其它几个也写解释
Q
张严
2026年03月04日 00:38
问题编号: 12213

外周血片如图所示,箭头所指示的是
A.棒状小体
B.Howell-Jolly小体
C.Dohle体
D.中毒颗粒
E.空泡
问1:没有图
Q
张严
2026年03月04日 00:32
问题编号: 12193

尿沉渣镜检如图所示,图中为
A.红细胞管型
B.蜡样管型
C.粗颗粒管型
D.细颗粒管型
E.透明管型
问1:没有图
Q
X0603016
2026年03月03日 16:10
问题编号: 44021
诊断心肌损伤特异性最高的酶是
A.Mb
B.CK-MB
C.cTn
D.LDH
E.BNP
A.Mb
B.CK-MB
C.cTn
D.LDH
E.BNP
问1:不是心肌肌钙蛋白吗
Q
张严
2026年03月03日 15:49
问题编号: 9252
轻型β珠蛋白生成障碍性贫血红细胞直方图特点是
A.峰右移,底变宽
B.峰左移,底无改变
C.峰左移,底变宽
D.峰左移,底变窄
E.峰右移,底变窄
A.峰右移,底变宽
B.峰左移,底无改变
C.峰左移,底变宽
D.峰左移,底变窄
E.峰右移,底变窄
问1:这题应该选B吧
Q
Jingjing er
2026年03月03日 14:20
问题编号: 41939
某患者,女性,20岁,四肢关节疼痛7月近日加重,来医院就诊,怀疑自身免疫病。
第3问:用免疫荧光法检测ANA有多种核型,下图属于

A.均质型
B.核膜型
C.胞质型
D.斑点型
E.核仁型
第3问:用免疫荧光法检测ANA有多种核型,下图属于

A.均质型
B.核膜型
C.胞质型
D.斑点型
E.核仁型
问1:看不到图
Q
张严
2026年03月03日 13:56
问题编号: 9171
造血负向调控的细胞因子是
A.转化生长因子β
B.生长因子
C.血小板衍生生长因子
D.干细胞因子
E.白血病抑制因子
A.转化生长因子β
B.生长因子
C.血小板衍生生长因子
D.干细胞因子
E.白血病抑制因子
问1:E选项也是负向调控因子
Q
张严
2026年03月02日 21:29
问题编号: 12407
自动生化仪上电极法快速检测血浆或血清葡萄糖浓度的原理是
A.葡萄糖氧化酶法-过氧化物酶偶联法
B.己糖激酶法
C.葡萄糖氧化酶氧速率法
D.葡萄糖脱氢酶法
E.Folin-Wu法
A.葡萄糖氧化酶法-过氧化物酶偶联法
B.己糖激酶法
C.葡萄糖氧化酶氧速率法
D.葡萄糖脱氢酶法
E.Folin-Wu法
问1:这题选a吗
Q
张严
2026年03月02日 19:56
问题编号: 10344
磷的主要生理功能为
A.镁与钙在体内具有协同作用
B.对神经、肌肉的兴奋性有镇静作用
C.构成核苷酸类辅酶
D.调节渗透压
E.维持酸碱平衡
A.镁与钙在体内具有协同作用
B.对神经、肌肉的兴奋性有镇静作用
C.构成核苷酸类辅酶
D.调节渗透压
E.维持酸碱平衡
问1:选维持酸碱平衡
Q
张严
2026年03月02日 19:17
问题编号: 10261
f-PSA/t-PSA比值为多少时可作为前列腺肥大和前列腺癌的鉴别点
A.0.15
B.0.20
C.0.25
D.0.30
E.0.35
A.0.15
B.0.20
C.0.25
D.0.30
E.0.35
问1:这题应该选0.25
Q
张严
2026年03月02日 00:51
问题编号: 12905
患者,女,45岁。临床表现为周期性深呼吸,疲乏感,动脉血气结果:pH7.15,SB20mmol/L,PCO₂30mmHg,BE5mmol/L,AB19mmol/L,考虑为
A. 代偿型代谢性酸中毒
B. 代偿型呼吸性酸中毒
C. 失代偿型呼吸性碱中毒
D. 代偿型代谢性碱中毒
E. 失代偿型代谢性酸中毒
A. 代偿型代谢性酸中毒
B. 代偿型呼吸性酸中毒
C. 失代偿型呼吸性碱中毒
D. 代偿型代谢性碱中毒
E. 失代偿型代谢性酸中毒
问1:BE应该为负值
Q
香哒哒
2026年03月01日 14:50
问题编号: 43846
关于耳垂采血的叙述,错误的是
A.痛感较轻
B.操作方便
C.受温度影响不大
D.检查结果不够恒定
E.红细胞测定结果比静脉血高
A.痛感较轻
B.操作方便
C.受温度影响不大
D.检查结果不够恒定
E.红细胞测定结果比静脉血高
问1:这题d不是也是错的吗
Q
刷题刷题
2026年03月01日 12:03
问题编号: 31341
患者男,21岁,发热,鼻出血,血红蛋白85g/L,脾肋下5cm,骨髓增生明显活跃,红细胞系统占61%,幼红细胞呈巨幼样变,原始细胞34%,该患者最可能的诊断是
A.巨幼细胞性贫血
B.铁粒幼细胞性贫血
C.AML-M1
D.AML-M6
E.溶血性贫血
A.巨幼细胞性贫血
B.铁粒幼细胞性贫血
C.AML-M1
D.AML-M6
E.溶血性贫血
问1:本题的题目解析中M5b:原单+幼单大于等于30%(ANC),应该是所有有核细胞而不是非红系细胞吧
Q
张严
2026年03月01日 11:03
问题编号: 13257
去除过度标记的荧光抗体最好用
A. 搅拌法
B. 透析法
C. 盐析法
D. 凝胶过滤法
E. 离子交换层析法
A. 搅拌法
B. 透析法
C. 盐析法
D. 凝胶过滤法
E. 离子交换层析法
问1:纯化抗体,去除过度标记应该是选凝胶过滤法
Q
张严
2026年03月01日 10:45
问题编号: 13244
患儿,男,10岁。发热1周,并有咽喉痛,咽峡炎。体检发现:颈部淋巴结肿大,扁桃体肿痛。血常规:RBC4.0×10^12/L,Hb130g/L,WBC12×10^9/L,PLT210×10^9/L。白细胞分类:中性成熟粒细胞81%,淋巴细胞13%,嗜酸性粒细胞2%,单核细胞4%,原始细胞未见。
血涂片检查最可能出现
A. 中毒颗粒和空泡变性
B. 原始及幼稚淋巴细胞
C. 卫星核淋巴细胞
D. 涂抹细胞
E. 异型淋巴细胞
血涂片检查最可能出现
A. 中毒颗粒和空泡变性
B. 原始及幼稚淋巴细胞
C. 卫星核淋巴细胞
D. 涂抹细胞
E. 异型淋巴细胞
问1:血涂片出现中毒颗粒和空泡
Q
葫芦
2026年02月28日 23:17
问题编号: 41982
患者红细胞计数为 2.4X10^12/L,白细胞计数为 180X10^9/L,其红细胞计数结果报告应为
A.2.01X10^12/L
B.2.11X10^12/L
C.2.12X10^12/L
D.2.22X10^12/L
E.2.32X10^12/L
A.2.01X10^12/L
B.2.11X10^12/L
C.2.12X10^12/L
D.2.22X10^12/L
E.2.32X10^12/L
问1:只能算得,看不懂
Q
刷题刷题
2026年02月28日 21:49
问题编号: 31260
为区别小原粒细胞性白血病与急性淋巴细胞白血病首选
A.铁染色
B.CAE染色
C.POX染色
D.PAS染色
E.NAP染色
A.铁染色
B.CAE染色
C.POX染色
D.PAS染色
E.NAP染色
问1:为什么不选糖原染色呢
Q
15708558395
2026年02月28日 21:21
问题编号: 33845
离子交换层析的主要原理是利用物质
A.在两相的吸附不同
B.在两相的溶解不同
C.分子大小不同
D.离子交换不同
E.亲和力不同
A.在两相的吸附不同
B.在两相的溶解不同
C.分子大小不同
D.离子交换不同
E.亲和力不同
问1:这个明明选D
Q
WyuEe
2026年02月28日 19:12
问题编号: 35498
在II型超敏反应中
A.细胞毒性抗体直接引起靶细胞溶解
B.Tc细胞参与反应而导致细胞被杀伤
C.组胺的释放在早期起重要作用
D.补体活化导致细胞或组织损伤的机制
E.中性粒细胞杀伤作用导致组织损伤
A.细胞毒性抗体直接引起靶细胞溶解
B.Tc细胞参与反应而导致细胞被杀伤
C.组胺的释放在早期起重要作用
D.补体活化导致细胞或组织损伤的机制
E.中性粒细胞杀伤作用导致组织损伤
问1:为什么不选A
Q
nervevaone
2026年02月28日 08:09
问题编号: 42076
乙肝病毒存在的直接标志是
A.HBsAg
B.HBeAg
C.HBcAg
D.HBcAb
E.HBeAb
A.HBsAg
B.HBeAg
C.HBcAg
D.HBcAb
E.HBeAb
问1:核心抗原测不到啊
Q
1577963408
2026年02月28日 01:48
问题编号: 41939
某患者,女性,20岁,四肢关节疼痛7月近日加重,来医院就诊,怀疑自身免疫病。
第3问:用免疫荧光法检测ANA有多种核型,下图属于

A.均质型
B.核膜型
C.胞质型
D.斑点型
E.核仁型
第3问:用免疫荧光法检测ANA有多种核型,下图属于

A.均质型
B.核膜型
C.胞质型
D.斑点型
E.核仁型
问1:又没图
Q
1577963408
2026年02月28日 01:12
问题编号: 42106
HPLC法测定糖化血红蛋白时需定期更换如图所示配件,在更换时应注意
A.方向
B.温度
C.湿度
D.清洁
E.浓度
A.方向
B.温度
C.湿度
D.清洁
E.浓度
问1:图在哪?
Q
15708558395
2026年02月27日 20:42
问题编号: 33687
符合垂体腺瘤性甲亢的试验结果是
A.T3T4↑、TSH↓、TRH兴奋试验(-)
B.T3T4↓、TSH↓、TRH兴奋试验(-)
C.T3T4↑、TSH↑、TRH兴奋试验(-)
D.T3T4↑、TSH↑、TRH兴奋试验(+)
E.T3T4↓、TSH↑、TRH兴奋试验(+)
A.T3T4↑、TSH↓、TRH兴奋试验(-)
B.T3T4↓、TSH↓、TRH兴奋试验(-)
C.T3T4↑、TSH↑、TRH兴奋试验(-)
D.T3T4↑、TSH↑、TRH兴奋试验(+)
E.T3T4↓、TSH↑、TRH兴奋试验(+)
问1:怎么老是答案错误啊,
Q
圆圆圈圈
2026年02月27日 13:45
问题编号: 36926
可用来检测霍乱弧菌的霍乱毒素
A.兔肠段结扎试验
B.豚鼠角膜试验
C.Hep-2细胞粘附试验
D.氧化酶试验
E.O/129敏感试验
A.兔肠段结扎试验
B.豚鼠角膜试验
C.Hep-2细胞粘附试验
D.氧化酶试验
E.O/129敏感试验
问1:其他选项都是查什么
Q
刷题刷题
2026年02月26日 20:59
问题编号: 31076
骨髓活检对下列贫血诊断有重要价值的是
A.缺铁性贫血
B.再生障碍性贫血
C.溶血性贫血
D.感染性贫血
E.巨幼细胞性贫血
A.缺铁性贫血
B.再生障碍性贫血
C.溶血性贫血
D.感染性贫血
E.巨幼细胞性贫血
问1:AA是支持性诊断,巨幼贫是肯定性诊断,为什么不选巨幼贫呢?
Q
15708558395
2026年02月26日 12:54
问题编号: 33599
患者女性,45岁。有慢性肾炎病史20年,近一月来下肢水肿,血压20/13.5kPa,尿蛋白定量3g/d,血肌酐215μmol/L,其蛋白尿性质最可能为
A.低分子蛋白尿
B.中分子蛋白尿
C.髙分子蛋白尿
D.组织性蛋白尿
E.混合性蛋白尿
A.低分子蛋白尿
B.中分子蛋白尿
C.髙分子蛋白尿
D.组织性蛋白尿
E.混合性蛋白尿
问1:应该选择C
Q
bsbg
2026年02月25日 08:44
问题编号: 32283
下列不能作为糖尿病诊断依据的是
A.糖尿病症状加随意静脉血浆葡萄糖≥11.lmmol/L
B.尿糖
C.空腹静脉血浆葡萄糖≥7.0mmol/L
D.OGTT时,2小时静脉血浆葡萄糖≥11.lmmol/L
E.空腹静脉血浆葡萄糖≥6.99mmol/L
A.糖尿病症状加随意静脉血浆葡萄糖≥11.lmmol/L
B.尿糖
C.空腹静脉血浆葡萄糖≥7.0mmol/L
D.OGTT时,2小时静脉血浆葡萄糖≥11.lmmol/L
E.空腹静脉血浆葡萄糖≥6.99mmol/L
问1:到底是6.99还是7.0呢 虽然知道尿糖做不了标准 但是怎么两个参考值呢
Q
15319102221
2026年02月23日 23:43
问题编号: 32814
[患者男性,24岁。近半年来腹部不适,多次剧烈腹痛。空腹12小时抽血分离血浆,呈奶样乳白色,但经15000转/分、离心30分钟后,发现血浆下层较透明,而表面为奶油层。]
该患者可能为下列哪种高脂血症
A.I型
B.II型
C.III型
D.IV型
E.V型
该患者可能为下列哪种高脂血症
A.I型
B.II型
C.III型
D.IV型
E.V型
问1:这道题 下层都变清了 为啥还是VLDL高
Q
15708558395
2026年02月23日 19:34
问题编号: 33197
肝炎
A.血清铁降低,总铁结合力增髙
B.血清铁增髙,总铁结合力降低
C.血清铁、总铁结合力均增髙
D.血淸铁、总铁结合力均降低
E.血淸铁增髙,总铁结合力正常
A.血清铁降低,总铁结合力增髙
B.血清铁增髙,总铁结合力降低
C.血清铁、总铁结合力均增髙
D.血淸铁、总铁结合力均降低
E.血淸铁增髙,总铁结合力正常
问1:这个题应该选D
Q
JXH
2026年02月22日 16:32
问题编号: 41294
患者男,61岁。因多饮、多尿、体重减轻就诊。血清生化检查结果:血糖10.1mmol/L,初步诊断为糖尿病。拟做尿糖检测,检查尿糖的最佳标本是
A.24小时尿
B.3小时尿
C.随机尿
D.晨尿
E.导尿标本
A.24小时尿
B.3小时尿
C.随机尿
D.晨尿
E.导尿标本
问1:C答案是随机尿,按道理应该选择B
Q
nervevaone
2026年02月22日 14:18
问题编号: 41537
关于糖代谢的说法不正确的是
A.胰高血糖素主要通过提高靶细胞内cAMP含量调节血糖
B.无氧酵解体内糖代谢最主要的途径
C.调节血糖激素主要包括生长激素,甲状腺激素
D.糖原的合成、分解、异生均在肝细胞内完成
E.受神经、激素和器官调节
A.胰高血糖素主要通过提高靶细胞内cAMP含量调节血糖
B.无氧酵解体内糖代谢最主要的途径
C.调节血糖激素主要包括生长激素,甲状腺激素
D.糖原的合成、分解、异生均在肝细胞内完成
E.受神经、激素和器官调节
问1:无氧糖酵解不是主要的糖代谢途径
Q
nervevaone
2026年02月21日 21:46
问题编号: 43081
关于镰状细胞贫血等叙述不正确的是
A.常染色体显性遗传疾病
B.主要见于东南亚黄种人
C.碱性血红蛋白电泳可见HbS带
D.HbS在脱氧状态下易发生镰变
E.病变为血红蛋白β链上第6位的谷氨酸被缬氨酸替代
A.常染色体显性遗传疾病
B.主要见于东南亚黄种人
C.碱性血红蛋白电泳可见HbS带
D.HbS在脱氧状态下易发生镰变
E.病变为血红蛋白β链上第6位的谷氨酸被缬氨酸替代
问1:镰状细胞贫血是常染色体隐性遗传病
Q
刷题刷题
2026年02月21日 18:28
问题编号: 32956
骨ALP增加通常不见于
A.骨折愈合过程
B.恶性肿瘤转移性骨损伤
C.Rickets病
D.Paget病
E.肝癌
A.骨折愈合过程
B.恶性肿瘤转移性骨损伤
C.Rickets病
D.Paget病
E.肝癌
问1:ALP2不是来自肝脏吗,肝癌时ALP不会增加?
Q
葫芦
2026年02月21日 11:58
问题编号: 44034
连续监测法测定ALT活性,标本量(v)10ul,试剂量 350ul,比色杯光径(L)1cm(340nm处NADH摩尔消光系数 E=6.3X10^3),经计算K值【K=(TV/SV)*(1/E)*(1/L)*10^6】为
A.6508
B.5714
C.4920
D.4127
E.3915
A.6508
B.5714
C.4920
D.4127
E.3915
问1:这题怎么算
Q
nervevaone
2026年02月20日 23:47
问题编号: 42298
免疫组织化学蛋白质类抗原的固定最常选用的固定剂或固定方法是
A.福尔马林
B.加热
C.乙醇或者甲醇
D.丙酮
E.盐酸
A.福尔马林
B.加热
C.乙醇或者甲醇
D.丙酮
E.盐酸
问1:免疫组化应该是福尔马林
Q
19984079271
2026年02月19日 11:04
问题编号: 46358
患者,女,60岁。头晕3个月,贫血近1年。外周血检查:Hb75g/L,RBC2.9×10^12/L,HCT0.261,ESR3mm/h,外周血涂片可见红细胞大小不均,中央淡染区扩大。
该患者最可能为
A. 再生障碍性贫血
B. 急性溶血性贫血
C. 缺铁性贫血
D. 巨幼红细胞贫血
E. 慢性失血性贫血
该患者最可能为
A. 再生障碍性贫血
B. 急性溶血性贫血
C. 缺铁性贫血
D. 巨幼红细胞贫血
E. 慢性失血性贫血
问1:老师好。麻烦教我算一下MCV。我算出来是89 不是小细胞 是不是没算对
Q
魏康
2026年02月18日 19:23
问题编号: 29108
血中哪一种胆红素增加会在尿中出现胆红素
A.总胆红素
B.直接胆红素
C.间接胆红素
D.结合胆红素
E.未结合胆红素
A.总胆红素
B.直接胆红素
C.间接胆红素
D.结合胆红素
E.未结合胆红素
问1:这一类题都不太会,能记住口诀不会应用
Q
魏康
2026年02月18日 19:22
问题编号: 29107
患阻塞性黄疸时
A.肝胆管内压力增高,导致毛细血管破裂,结合胆红素不能排入肠道而逆流入血
B.肝细胞对胆红素的摄取、结合、排泄功能受损
C.大量红细胞遭破坏,形成大量未结合胆红素,超过肝细胞的摄取、结合、排泄能力
D.肝细胞摄取胆红素功能障碍及微粒体内葡萄糖醛酸转移酶不足
E.肝细胞摄取未结合胆红素能力减低,使UCB在血中浓度增高,但仍能将UCB转变为CB
A.肝胆管内压力增高,导致毛细血管破裂,结合胆红素不能排入肠道而逆流入血
B.肝细胞对胆红素的摄取、结合、排泄功能受损
C.大量红细胞遭破坏,形成大量未结合胆红素,超过肝细胞的摄取、结合、排泄能力
D.肝细胞摄取胆红素功能障碍及微粒体内葡萄糖醛酸转移酶不足
E.肝细胞摄取未结合胆红素能力减低,使UCB在血中浓度增高,但仍能将UCB转变为CB
问1:不动思路,分辨不清
Q
绛珠
2026年02月15日 22:38
问题编号: 31740
对血管有收缩作用的物质是
A.儿茶酚胺、FPA
B.乙酰胆碱、激肽
C.PGI2、低血氧
D.5-HT
E.NO、核苷酸
A.儿茶酚胺、FPA
B.乙酰胆碱、激肽
C.PGI2、低血氧
D.5-HT
E.NO、核苷酸
问1:A的两种物质不也是收缩物质吗,为什么不对
Q
圆圆圈圈
2026年02月15日 17:15
问题编号: 37885
[患者女性,45岁。3天前突发高热,寒战,腰痛,并有尿频、尿急及排尿疼痛。查体:T39℃,右脊肋区压痛及叩击痛,尿检:外观混独,RBC8/HP,WBC30/HP,临床诊断为急性肾盂肾炎。]
对该菌所致尿路感染具有有诊断意义的菌落计数为
A.>l0^3CFU/ml
B.>l0^4CFU/ml
C.l0^4-10^5CFU/ml
D.小于l0^5CFU/ml
E.>l0^5CFU/ml
对该菌所致尿路感染具有有诊断意义的菌落计数为
A.>l0^3CFU/ml
B.>l0^4CFU/ml
C.l0^4-10^5CFU/ml
D.小于l0^5CFU/ml
E.>l0^5CFU/ml
问1:怎么断定是革兰阴性菌还是革兰阳性菌呢
Q
19984079271
2026年02月15日 11:23
问题编号: 33051
严重腹泻患者常引起
A.血[Na+]、[HCO3-]上升
B.代谢性碱中毒
C.血中CO2结合力上升
D.低血钾
E.血液pH增高
A.血[Na+]、[HCO3-]上升
B.代谢性碱中毒
C.血中CO2结合力上升
D.低血钾
E.血液pH增高
问1:刚才有一题的解析说低血钾引起代谢性碱中毒,这题腹泻丢失钾是引起低血钾,为什么又会是引起代谢性酸中毒。麻烦老师解答一下
Q
19984079271
2026年02月14日 15:39
问题编号: 28872
酸性尿液中红细胞的形态为()。
A.皱缩、体积小,呈桑葚形
B.体积膨胀、无色
C.存在一定时间,但体积小
D.边缘不规则
E.容易破裂,形成褐色颗粒
A.皱缩、体积小,呈桑葚形
B.体积膨胀、无色
C.存在一定时间,但体积小
D.边缘不规则
E.容易破裂,形成褐色颗粒
问1:麻烦解释一下其他几个选项是什么情况出现
Q
香哒哒
2026年02月13日 21:28
问题编号: 41482
关于白蛋白等叙述错误的是
A.等电点4.7左右
B.带负电荷
C.能结合Ca2+、Mg2+、Cu2+等正离子
D.运载水溶性药物
E.运载类固醇激素、脂肪酸等
A.等电点4.7左右
B.带负电荷
C.能结合Ca2+、Mg2+、Cu2+等正离子
D.运载水溶性药物
E.运载类固醇激素、脂肪酸等
问1:这题是不是矛盾
Q
tzbwx
2026年02月11日 16:58
问题编号: 28338
血涂片镜检如图2所示,剪头所指的是

A.红细胞裂片
B.口形红细胞
C.球形红细胞
D.靶形红细胞
E.低色素红细胞
A.红细胞裂片
B.口形红细胞
C.球形红细胞
D.靶形红细胞
E.低色素红细胞
问1:这道题图片没显示箭头
Q
19984079271
2026年02月11日 16:13
问题编号: 28473
能分化为浆细胞产生抗体的细胞是
A.NK细胞
B.T细胞
C.B细胞
D.中性粒细胞
E.嗜碱性粒细胞
A.NK细胞
B.T细胞
C.B细胞
D.中性粒细胞
E.嗜碱性粒细胞
问1:B细胞分化为浆细胞产生抗体,选B还是C
Q
19984079271
2026年02月11日 11:10
问题编号: 32587
以下哪种情况可引起结合珠蛋白含量明显下降
A.血管内溶血
B.恶性肿瘤
C.严重感染
D.严重肝病
E.组织损伤
A.血管内溶血
B.恶性肿瘤
C.严重感染
D.严重肝病
E.组织损伤
问1:在肝细胞内合成,严重肝病的时候没有明显下降吗?
Q
mm12123
2026年02月10日 23:45
问题编号: 33618
注射吗啡时可见
A.血清淀粉酶活性升高伴尿淀粉酶活性降低
B.血清淀粉酶活性升高以S型为主,36小时恢复正常
C.血清S型淀粉酶和P型淀粉酶可同时升高,也可为此两型中任何一型升高
D.血和尿淀粉酶活性升高伴脂肪酶活性升高
E.血清S型淀粉酶升高而P型淀粉酶正常,脂肪酶活性不升高
A.血清淀粉酶活性升高伴尿淀粉酶活性降低
B.血清淀粉酶活性升高以S型为主,36小时恢复正常
C.血清S型淀粉酶和P型淀粉酶可同时升高,也可为此两型中任何一型升高
D.血和尿淀粉酶活性升高伴脂肪酶活性升高
E.血清S型淀粉酶升高而P型淀粉酶正常,脂肪酶活性不升高
问1:解析一下这题喂,知识盲区啊
Q
葫芦
2026年02月10日 20:56
问题编号: 43278
某校多名学生在食堂进餐后数小时出现恶心,呕吐症状,取剩余食物做细菌培养,培养物呈金黄色,可产生血浆凝固酶,可分解甘露醇,此菌的其他特点是
A.可形成双层溶血环
B.人是其唯一宿主
C.胆汁溶菌试验阳性
D.致病物质有SPA
E.不耐低温
A.可形成双层溶血环
B.人是其唯一宿主
C.胆汁溶菌试验阳性
D.致病物质有SPA
E.不耐低温
问1:SPA是什么
Q
葫芦
2026年02月10日 20:56
问题编号: 43277
前列腺癌患者增加的血清酶是
A.PCHE
B.ALT
C.NAG
D.GGT
E.ACP
A.PCHE
B.ALT
C.NAG
D.GGT
E.ACP
问1:ACP是什么
Q
1146823769
2026年02月10日 10:26
问题编号: 39490
患者女,临床表现为周期性深呼吸,疲乏感,动脉血气结果:pH7.35,SB20mmol/L,PCO230mmHg,BE-5mmol/L,AB19mmol/L,考虑为
A.代偿型代谢性酸中毒
B.代偿型呼吸性酸中毒
C.代偿型呼吸性碱中海
D.代偿型代谢性碱中毐
E.无酸碱平衡紊乱
A.代偿型代谢性酸中毒
B.代偿型呼吸性酸中毒
C.代偿型呼吸性碱中海
D.代偿型代谢性碱中毐
E.无酸碱平衡紊乱
问1:PH值正常值不是7.35-7.45吗?为什么7.35是降低???
Q
hcy
2026年02月09日 18:36
问题编号: 42301
医疗卫生资源分配最基本的伦理原则是
A. 公平
B. 公正
C. 公用
D. 效用
E. 效益
A. 公平
B. 公正
C. 公用
D. 效用
E. 效益
问1:公平是a 答案b显示也是公平
Q
Liuqians
2026年02月09日 18:07
问题编号: 39306
为鉴别炭疽芽孢杆菌和类炭疽杆菌,将待检菌接种于含0.3U/ml青霉素的培养基上,35℃培养6小时后,培养物亚甲蓝染色显微镜下观察如图所示。由此可以判断此菌为

A.枯草芽孢杆菌
B.腊样芽孢杆菌
C.苏云金芽孢杆菌
D.炭疽芽孢杆菌
E.巨大芽孢杆菌

A.枯草芽孢杆菌
B.腊样芽孢杆菌
C.苏云金芽孢杆菌
D.炭疽芽孢杆菌
E.巨大芽孢杆菌
问1:图呢?
Q
WyuEe
2026年02月09日 18:02
问题编号: 29324
尿糖测定(葡萄糖氧化酶法)引起假阳性的物质是
A.维生素C
B.左旋多巴
C.试剂带被氧化物污染
D.尿中含对氧亲和力强的物质
E.尿标本放置过久
A.维生素C
B.左旋多巴
C.试剂带被氧化物污染
D.尿中含对氧亲和力强的物质
E.尿标本放置过久
问1:C为什么不对
Q
xueshuang111
2026年02月09日 11:11
问题编号: 34188
临床进行ABO血型鉴定最常采用的方法为
A.间接凝集反应
B.玻片凝集法
C.试管凝集法
D.间接凝集抑制反应
E.沉淀反应
A.间接凝集反应
B.玻片凝集法
C.试管凝集法
D.间接凝集抑制反应
E.沉淀反应
问1:最常用不是试管凝集吗,考试的时候怎么选呢
Q
葫芦
2026年02月09日 09:20
问题编号: 45583
[患者男,73岁。头晕乏力半年伴牙龈出血1个月。体检:贫血外观,脾肋下1cm,,实验室检查:全血细胞减少,骨髓增生活跃,巨幼红细胞5%,有类巨样变,血涂片可见不典型小巨核细胞。]
进一步诊断是
A.骨髓穿刺
B.淋巴结活检
C.外周血涂片
D.化学染色
E.影像学检查
进一步诊断是
A.骨髓穿刺
B.淋巴结活检
C.外周血涂片
D.化学染色
E.影像学检查
问1:MDS是什么
Q
nervevaone
2026年02月08日 23:39
问题编号: 44143
患者女,40岁。因半年来体重下降20多斤而就诊。无明显多饮,多食,多尿,无心慌,气短,多汗,怕热,烦躁。既往体健。无药物过敏史。个人史及家庭史无特殊。查体:T36‘C,P80次/分,R18次/分,BP120/80mmHg。查体未见异常。实验室检查:HB120g/L,WBC7.6X109/L,PLT267X109/L。尿常规:尿蛋白(-),尿糖(++),空腹血糖10.7mmol/L。最可能的诊断是
A.甲状腺功能亢进
B.恶性肿瘤
C.1型糖尿病
D.2型糖尿病
E.胰岛细胞瘤
A.甲状腺功能亢进
B.恶性肿瘤
C.1型糖尿病
D.2型糖尿病
E.胰岛细胞瘤
问1:2型糖尿病
Q
香哒哒
2026年02月08日 21:12
问题编号: 41660
住院病人血钾危急值需要怎么处理
A.告知医生
B.告知院长
C.告知患者家属
D.重复检验,并报告检验科主任
E.不做处理直接发报告
A.告知医生
B.告知院长
C.告知患者家属
D.重复检验,并报告检验科主任
E.不做处理直接发报告
问1:为啥不是D选项
Q
nervevaone
2026年02月08日 16:23
问题编号: 44021
诊断心肌损伤特异性最高的酶是
A.Mb
B.CK-MB
C.cTn
D.LDH
E.BNP
A.Mb
B.CK-MB
C.cTn
D.LDH
E.BNP
问1:应该是cTn
Q
19984079271
2026年02月08日 11:17
问题编号: 40733
空腹血糖6.2mmol/L,HbA1C8.2%,判断患者可能
A.新发生的糖尿病患者
B.误饮高糖饮料的健康人
C.血糖控制患者
D.无糖尿病
E.糖耐量受损的患者
A.新发生的糖尿病患者
B.误饮高糖饮料的健康人
C.血糖控制患者
D.无糖尿病
E.糖耐量受损的患者
问1:题干中并没有提到餐后两小时血糖,二十八糖化血红蛋白,以此来判断糖耐量受损是否缺乏依据。糖化8.2明显升高,空腹血糖6.2,如果新发生的糖尿病人处于血糖控制期,而因为未发现前血糖高所以糖化高,这样理解是否更加可行
Q
15021821575
2026年02月07日 22:25
问题编号: 40180
引起血沉减慢的疾病是
A.风湿热
B.结核病
C.心肌梗死
D.高球蛋白血症
E.真性红细胞增多症
A.风湿热
B.结核病
C.心肌梗死
D.高球蛋白血症
E.真性红细胞增多症
问1:血沉升高或降低疾病
Q
WyuEe
2026年02月06日 20:49
问题编号: 32807
某实验室收到一个血标本,经离心后上层血清呈云雾状浑浊,其原因可能是由于
A.胆固醇增髙
B.甘油三酯增高
C.LDL增高
D.HDL增高
E.磷脂增高
A.胆固醇增髙
B.甘油三酯增高
C.LDL增高
D.HDL增高
E.磷脂增高
问1:为什么不选C
Q
WyuEe
2026年02月06日 20:19
问题编号: 30416
正常骨髓象不包括
A.偶见内皮细胞
B.粒红比例3-4:1
C.容易见到核分类象
D.小儿淋巴细胞可高达40%
E.原始红细胞<1%,早幼红细胞<5%
A.偶见内皮细胞
B.粒红比例3-4:1
C.容易见到核分类象
D.小儿淋巴细胞可高达40%
E.原始红细胞<1%,早幼红细胞<5%
问1:核分类象是什么
Q
19984079271
2026年02月06日 15:51
问题编号: 40949
不经糖异生途径可合成葡萄糖的物质是
A.a-磷酸甘油
B.丙酮酸
C.乳酸
D.乙酰CoA
E.生糖氨基酸
A.a-磷酸甘油
B.丙酮酸
C.乳酸
D.乙酰CoA
E.生糖氨基酸
问1:题目是不是有误
不可经过糖异生途径合成葡萄糖的物质?
Q
hcy
2026年02月06日 14:05
问题编号: 40961
某战士长时间行军出现血尿,形成血尿的原因是由于尿中含有
A.肌钙蛋白
B.血红蛋白
C.红细胞
D.肌红蛋白
E.胆红素
A.肌钙蛋白
B.血红蛋白
C.红细胞
D.肌红蛋白
E.胆红素
问1:解析是d 答案是b
Q
郝苗苗
2026年02月06日 13:04
问题编号: 31299
有关M0实验诊断免疫学检查的叙述错误的是
A.免疫细胞化学MPO阳性
B.免疫表型表达为髓系分化抗原CD13,CD33,CD14,CD15,CD11b中至少有一种阳性。
C.可表达B系特异性抗原或T系特异性抗原
D.可表达未成熟标志CD34,TdT,HLA-DR
E.可免疫细胞化学MPO阴性,但表达髓系分化抗原
A.免疫细胞化学MPO阳性
B.免疫表型表达为髓系分化抗原CD13,CD33,CD14,CD15,CD11b中至少有一种阳性。
C.可表达B系特异性抗原或T系特异性抗原
D.可表达未成熟标志CD34,TdT,HLA-DR
E.可免疫细胞化学MPO阴性,但表达髓系分化抗原
问1:可以解释下A和E项吗
Q
nervevaone
2026年02月06日 08:56
问题编号: 43751
关于硫磺样颗粒的叙述,不正确的是
A.为分支缠绕的小菌落
B.压片后镜下观察呈菊花状
C.中央为革兰阳性丝状体
D.周围是粗大的革兰阴性棒状体
E.病理标本经苏木精染色呈红色
A.为分支缠绕的小菌落
B.压片后镜下观察呈菊花状
C.中央为革兰阳性丝状体
D.周围是粗大的革兰阴性棒状体
E.病理标本经苏木精染色呈红色
问1:不应该选D吗,棒状体不是细菌,无法染色
Q
llll
2026年02月05日 23:44
问题编号: 30283
关于出生后造血,错误的是
A.淋巴器官产生淋巴细胞
B.出生后红细胞、白细胞、血小板均由骨髓产生
C.5~7岁以下幼儿几乎全部骨髄参与造血活动即为红髄
D.长骨骨髄腔为脂肪细胞所代替称为黄髄,即失去造血功能
E.正常情况下,成人主要的造血器官是骨髓
A.淋巴器官产生淋巴细胞
B.出生后红细胞、白细胞、血小板均由骨髓产生
C.5~7岁以下幼儿几乎全部骨髄参与造血活动即为红髄
D.长骨骨髄腔为脂肪细胞所代替称为黄髄,即失去造血功能
E.正常情况下,成人主要的造血器官是骨髓
问1:黄骨髓并没有失去造血功能哒
Q
mm12123
2026年02月05日 21:20
问题编号: 28409
[患者女性,15岁。一年来感头昏、眼花、乏力,不能劳动,经当地医院治疗后好转,未坚持治疗。近一月来上述症状加重就诊。体检:T36.7℃,R20次/分,P102次/分。贫血貌,肝脾未触及,下肢轻度水肿,全身未见出血点。诉平时喜食生花生,余无特殊。实验室检查:Hb60g/L,RBC3.5X10^12/L,血细胞比容0.22,RDW23.3%,WBC11X10^9/L,分类:N61%,L12%,M5%,E22%,PLT336X10^9/L。粪便隐血试验阳性]
患者外周血细胞形态学的改变不可能有
A.红细胞中心淡染区扩大
B.偶见晚幼红细胞
C.出现大量靶形红细胞
D.小红细胞增多
E.红细胞大小不均一
患者外周血细胞形态学的改变不可能有
A.红细胞中心淡染区扩大
B.偶见晚幼红细胞
C.出现大量靶形红细胞
D.小红细胞增多
E.红细胞大小不均一
问1:这题诊断的依据是啥呢?
Q
WyuEe
2026年02月05日 20:06
问题编号: 40589
患者男,62岁。头晕乏力半年伴牙龈出血1个月。查体:贫血外观,肝、脾肋下可触及。实验室检查:RBC3.8X10^12/L,HB77g/L,MCV和MCHC正常,WBC3.4X10^9/L,PLT65X10^9/L,血涂片可见幼红细胞。最可能的诊断为
A.铁粒幼细胞贫血
B.营养不良性贫血
C.脾功能亢进
D.再生障碍性贫血
E.MDS
A.铁粒幼细胞贫血
B.营养不良性贫血
C.脾功能亢进
D.再生障碍性贫血
E.MDS
问1:MDS不是大细胞均一性吗
Q
WyuEe
2026年02月05日 19:54
问题编号: 33443
肝性脑病时血中浓度降低的物质是
A.血氨
B.苯丙氨酸
C.酪氨酸
D.GABA
E.亮氨酸
A.血氨
B.苯丙氨酸
C.酪氨酸
D.GABA
E.亮氨酸
问1:为什么今后支链氨基酸降低
Q
香哒哒
2026年02月05日 16:43
问题编号: 45450
患者男,26岁。发热2周。查体:138.1℃,胸骨下段轻压痛,双侧颈部淋巴结肿大(约2cmx2cm),肝未触及,脾肋下2cm,实验室检查:血红蛋白98g/L,白细胞5.6x10/L,血小板193x10/L,分类示中性分叶核粒细胞52%。淋巴细胞33%。嗜酸性粒细胞9%,单核细胞6%。CT示:腹膜后淋巴结肿大,该患者最可能的诊断是
A.传染性单核细胞增多症
B.急性白血病
C.多发性骨髓瘤
D.骨髓增生异常综合征
E.淋巴瘤
A.传染性单核细胞增多症
B.急性白血病
C.多发性骨髓瘤
D.骨髓增生异常综合征
E.淋巴瘤
问1:单核细胞6%算啥呀
Q
My1314521
2026年02月05日 15:10
问题编号: 31911
一期止血缺陷常用的筛检试验是
A.PT和APTT
B.BT和BPC
C.BT和PT
D.APTT和BPC
E.BT和CT
A.PT和APTT
B.BT和BPC
C.BT和PT
D.APTT和BPC
E.BT和CT
问1:2题跟1题问题一模一样 答案不一样 1题解析也不够完整 我看了半天才看出来其实两个题的答案都是对的 只不过是第2题里面的BPC包含了PLT
Q
香哒哒
2026年02月05日 09:56
问题编号: 45381
轻型β珠蛋白生成障碍性贫血红细胞直方图特点是
A.峰右移,底变宽
B.峰左移,底无改变
C.峰左移,底变宽
D.峰左移,底变窄
E.峰右移,底变窄
A.峰右移,底变宽
B.峰左移,底无改变
C.峰左移,底变宽
D.峰左移,底变窄
E.峰右移,底变窄
问1:均一性不是不改变吗
Q
香哒哒
2026年02月05日 00:17
问题编号: 45287
患者女,50岁,3年前有肝炎史,HBsAg(+)、HBeAg(+)、抗-HBe(+),经治疗后好转,近来乏力纳差,查体:巩膜黄染,肝掌、蜘蛛痣,慢性肝病面容,肝肋下2cm,脾肋下刚及,ALT150U/L,类风湿因子(+),抗核抗体1:100(+)。该患者可初步诊断为()
A.慢性迁延型肝炎
B.慢性活动性肝炎
C.慢性重症肝炎
D.肝硬化
E.肝癌
A.慢性迁延型肝炎
B.慢性活动性肝炎
C.慢性重症肝炎
D.肝硬化
E.肝癌
问1:这道题出现不同的答案吗?前两天刷到是答案B
Q
刷题刷题
2026年02月04日 21:19
问题编号: 46233
由Ⅲ型超敏反应引起的疾病是
A. 血清过敏症
B. 接触性皮炎
C. 类风湿关节炎
D. 新生儿溶血症
E. 甲状腺功能亢进
A. 血清过敏症
B. 接触性皮炎
C. 类风湿关节炎
D. 新生儿溶血症
E. 甲状腺功能亢进
问1:这里的血清病不是三型超敏反应吗
Q
香哒哒
2026年02月04日 15:30
问题编号: 45813
患儿男,3岁。1年来感到走路不方便,特别是最近有些左右摇摆,像鸭步,并且从床上起来感到困难,实验室检测结果如下:CK5800U/L,LD2100U/L,AST124U/L,CK-MB345U/L,可诊断为
A.心肌炎
B.肌肉损伤
C.重症肌无力
D.多发性肌炎
E.肌营养不良
A.心肌炎
B.肌肉损伤
C.重症肌无力
D.多发性肌炎
E.肌营养不良
问1:为啥不是肌无力?
Q
WyuEe
2026年02月04日 11:58
问题编号: 31924
临床上以皮肤紫癜和黏膜出血为主要表现的疾病,应选用下列哪一组作为筛选性试验
A.束臂试验、血小板计数
B.活化的部分凝血活酶时间、凝血酶原时间、凝血酶时间
C.血小板计数、出血时间、血块收缩时间
D.血小板计数、凝血酶原时间、纤维蛋白原定量测定
E.凝血酶时间、纤维蛋白原定量测定、D-二聚体测定
A.束臂试验、血小板计数
B.活化的部分凝血活酶时间、凝血酶原时间、凝血酶时间
C.血小板计数、出血时间、血块收缩时间
D.血小板计数、凝血酶原时间、纤维蛋白原定量测定
E.凝血酶时间、纤维蛋白原定量测定、D-二聚体测定
问1:为什么不选C
Q
许小懒
2026年02月04日 01:37
问题编号: 43455
关于粪便镜检,错误的是
A.低倍镜观察白细胞
B.观察由上至下、由左至右
C.至少每张涂片观察10个视野
D.高倍镜观察原虫
E.用生理盐水稀释标本
A.低倍镜观察白细胞
B.观察由上至下、由左至右
C.至少每张涂片观察10个视野
D.高倍镜观察原虫
E.用生理盐水稀释标本
问1:D难道不对吗
Q
15021821575
2026年02月03日 23:08
问题编号: 40144
已知患者血糖值是180mg/dl(葡萄糖的分子量为180),以SI制表示为
A.8.86mmol/L
B.9.23mmol/L
C.10mmol/L
D.12.53mmol/L
E.14.88mmol/L
A.8.86mmol/L
B.9.23mmol/L
C.10mmol/L
D.12.53mmol/L
E.14.88mmol/L
问1:如何计算的?没看懂
Q
15021821575
2026年02月03日 23:06
问题编号: 40140
血涂片计数100个白细胞,见20个有核红细胞。如白细胞计数校正前为12x10^9/L,则校正
后实际应为
A.4x10^9/L
B.8x10^9/L
C.10x10^9/L
D.12.5x10^9/L
E.15x10^9/L
后实际应为
A.4x10^9/L
B.8x10^9/L
C.10x10^9/L
D.12.5x10^9/L
E.15x10^9/L
问1:NRBC是什么意思
Q
llll
2026年02月03日 21:21
问题编号: 29668
CSF采集的笫一管用于
A.细菌培养
B.蛋白质测定
C.免疫学检查
D.葡萄糖测定
E.显微镜检查
A.细菌培养
B.蛋白质测定
C.免疫学检查
D.葡萄糖测定
E.显微镜检查
问1:哪遇到的话应该依据那一版
Q
mm12123
2026年02月03日 20:57
问题编号: 41635
某地夏季突然出现腹泻病人群,发病人数在数日内迅速上升,但临床症状不典型,细菌学诊断中对病原菌的检验方法不推荐
A、分离培养
B、直接涂片镜检
C、血清学试验
D、动物试验
E.人体试验
A、分离培养
B、直接涂片镜检
C、血清学试验
D、动物试验
E.人体试验
问1:这个题目的知识点是啥?
问2:这个题目的知识点是啥?
问2:这个题目的知识点是啥?
Q
可爱
2026年02月03日 15:30
问题编号: 46334
患者,女,45岁。临床表现为周期性深呼吸,疲乏感,动脉血气结果:pH7.15,SB20mmol/L,PCO₂30mmHg,BE5mmol/L,AB19mmol/L,考虑为
A. 代偿型代谢性酸中毒
B. 代偿型呼吸性酸中毒
C. 失代偿型呼吸性碱中毒
D. 代偿型代谢性碱中毒
E. 失代偿型代谢性酸中毒
A. 代偿型代谢性酸中毒
B. 代偿型呼吸性酸中毒
C. 失代偿型呼吸性碱中毒
D. 代偿型代谢性碱中毒
E. 失代偿型代谢性酸中毒
问1:老师,血气的参考值发下。谢谢!
Q
资产郭亿
2026年02月03日 11:35
问题编号: 42242
患者,男,45岁。突然感觉胸痛,4小时后到医院就诊,心电图ST段抬高,以下哪项检查对于排除急性心肌梗死的首要指标
A. CK
B. CK-MB亚型
C. cTn
D. Mb
E. LDH
A. CK
B. CK-MB亚型
C. cTn
D. Mb
E. LDH
问1:参考答案提示的是什么
Q
圆圆圈圈
2026年02月02日 21:03
问题编号: 35793
下面描述与胚胎抗原无关的是
A.当细胞恶变时,此类抗原可重新合成
B.可以用于某种肿瘤的临床诊断
C.能引起宿主免疫系统对这种抗原的免疫应答
D.由胚胎组织产生
E.出生后逐渐消失或仅存留极微量
A.当细胞恶变时,此类抗原可重新合成
B.可以用于某种肿瘤的临床诊断
C.能引起宿主免疫系统对这种抗原的免疫应答
D.由胚胎组织产生
E.出生后逐渐消失或仅存留极微量
问1:老师,选项C到底是相关还是无关?